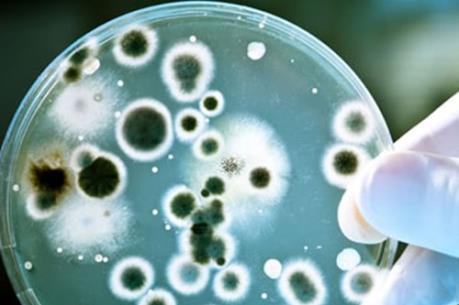
Siêu vi khuẩn kháng mọi kháng sinh đã xuất hiện tại Mỹ

BNEWS Ngày 27/6, giới chức khoa học Mỹ thông báo đã ghi nhận trường hợp thứ 2 mắc siêu vi khuẩn kháng tất cả mọi loại kháng sinh.
Trong một nghiên cứu đăng trên tạp chí của Hiệp hội Vi trùng học và vi sinh học của Mỹ, các nhà vi trùng học cho biết đã phát hiện gen đột biến MCR-1 hay plasmid trong chủng vi khuẩn E.coli ở một bệnh nhân sống tại New York.
Loại gen này khiến chủng E.coli trên trở thành siêu vi khuẩn có khả năng kháng tất cả các loại kháng sinh kể cả Colistin – một loại kháng sinh được xem là “của để dành cuối cùng” trong việc điều trị các bệnh hiểm nghèo.
Hồi tháng trước, giới chức y tế Mỹ đã phát hiện trường hợp đầu tiên nhiễm siêu vi khuẩn kháng mọi loại kháng sinh này. Tuy nhiên, nữ bệnh nhân 49 tuổi sống ở bang Pennsylvania này đã phục hồi.
MCR-1, nằm trong một đoạn thông tin di truyền (DNA) của vi khuẩn và có thể lây truyền sang các vi khuẩn khác qua 1 số giống loài. Theo các nhà khoa học, sự lây lan của siêu vi khuẩn này sẽ là sự khởi đầu của "một cơn ác mộng" về một đại dịch bệnh nhiễm trùng vô phương cứu chữa trên toàn cầu.
Các nhà khoa học bắt đầu theo dõi sự lây lan của loại gen MCR-1 kể từ khi loại siêu vi khuẩn này xuất hiện ở người, gia cầm và lợn tại Trung Quốc năm 2015. Hiện ở châu Âu cũng đã xuất hiện loại siêu vi khuẩn này.
Colistin là dòng kháng sinh thế hệ cũ, được đưa vào sử dụng từ năm 1950 để điều trị các bệnh nhiễm trùng do các vi khuẩn E.coli, Salmonella và Acinetobacter gây ra. Vào những năm 80 của thế kỷ trước, Colistin đã bị cấm sử dụng trên người do tác dụng phụ gây nhiễm độc ở thận, song vẫn được sử dụng rộng rãi trong chăn nuôi, đặc biệt là ở Trung Quốc.
Các nhà khoa học từng cảnh báo người ăn thịt chứa vi khuẩn “nhờn thuốc” cũng có nguy cơ cao bị nhiễm chính vi khuẩn này.
Theo thống kê, riêng tại Mỹ, tình trạng kháng kháng sinh đã khiến ít nhất 2 triệu người mắc bệnh và 23.000 người tử vong mỗi năm. Việc các bác sĩ và bệnh nhân lạm dụng kháng sinh cũng như việc sử dụng tràn lan loại dược phẩm này trong chăn nuôi đang trở thành một vấn đề nhức nhối, góp phần tạo nên cuộc “khủng hoảng kháng kháng sinh” hiện nay.
Các chuyên gia y tế khuyến cáo mọi người cần hạn chế sử dụng kháng sinh nếu không cần thiết, đồng thời nhấn mạnh cách phòng bệnh tốt nhất là tăng cường sức đề kháng, giữ gìn vệ sinh sạch sẽ cũng như tiêu thụ các thực phẩm hợp vệ sinh.
>>> Mỹ thiết lập mạng lưới phòng thí nghiệm ứng phó siêu vi khuẩn kháng thuốc
Tin liên quan
Mỹ thiết lập mạng lưới phòng thí nghiệm ứng phó siêu vi khuẩn kháng thuốc
Trung tâm Kiểm soát và Phòng ngừa dịch bệnh của Mỹ (CDC) đang thiết lập mạng lưới phòng thí nghiệm có khả năng ứng phó nhanh với siêu vi khuẩn kháng mọi loại thuốc kháng sinh (superbug).
Tin cùng chuyên mục
-
Kinh tế xã hộiThanh Hoá: Cơ bản dập tắt các đám cháy rừng tại phường Hải Bình
Theo thống kê sơ bộ của Sở Nông nghiệp và Môi trường Thanh Hóa, diện tích rừng bị ảnh hưởng do vụ cháy tại phường Hải Bình khoảng hơn 1,5 ha, kéo dài trên 2 khu vực đồi.
-
Kinh tế xã hộiThanh Hoá: Huy động gần 300 người khống chế đám cháy rừng
Chi cục Kiểm lâm Thanh Hoá cho biết, lực lượng chức năng đang huy động người và phương tiện khẩn trương chữa cháy rừng tại khu vực Đồi 174 thuộc Tổ dân phố Hữu Lại, Hữu Nhân, phường Hải Bình.
-
Kinh tế xã hộiBước chuyển mình của chính quyền sát dân
Bí thư Tỉnh ủy An Giang Nguyễn Tiến Hải khẳng định, việc tổ chức mô hình chính quyền địa phương 2 cấp là chủ trương đúng đắn, mang tính chiến lược nhằm tinh gọn bộ máy và nâng cao hiệu lực quản lý.
-
Kinh tế xã hộiLỗi kỹ thuật khiến nhiều người dân nhận tin nhắn cảnh báo bão từ năm 2024
Cục Quản lý Đê điều và Phòng chống thiên tai khuyến cáo người dân bình tĩnh, không chia sẻ các thông tin chưa được kiểm chứng, thông tin không chính xác.
-
Kinh tế xã hộiXSMB 25/6. Kết quả xổ số miền Bắc hôm nay ngày 25/6/2026. XSMB thứ Năm ngày 25/6
Bnews. XSMB 25/6. Kết quả xổ số hôm nay ngày 25/6. XSMB thứ Năm. Trực tiếp KQXSMB ngày 25/6. Kết quả xổ số miền Bắc hôm nay thứ Năm ngày 25/6/2026.
-
Kinh tế xã hộiXSMT 25/6. Kết quả xổ số miền Trung hôm nay ngày 25/6/2026. XSMT thứ Năm ngày 25/6
XSMT 25/6. KQXSMT 25/6/2026. Kết quả xổ số hôm nay ngày 25/6. XSMT thứ Năm. Xổ số miền Trung hôm nay 25/6/2026. Trực tiếp KQXSMT ngày 25/6. Kết quả xổ số miền Trung hôm nay thứ Năm ngày 25/6.
-
Kinh tế xã hộiXSMN 25/6. Kết quả xổ số miền Nam hôm nay ngày 25/6/2026. XSMN thứ Năm ngày 25/6
XSMN 25/6. KQXSMN 25/6/2026. Kết quả xổ số hôm nay ngày 25/6. XSMN thứ Năm. Xổ số miền Nam hôm nay 25/6/2026. Trực tiếp KQXSMN ngày 25/6. Kết quả xổ số miền Nam hôm nay thứ Năm ngày 25/6/2026.
-
Kinh tế xã hộiKết quả Vietlott Power 6/55 ngày 25/6 - Kết quả xổ số Vietlott ngày 25/6/2026 - Xổ số Vietlott Power 6/55 hôm nay
Bnews. Kết quả Vietlott Power 6/55 ngày 25/6. Kết quả xổ số Vietlott hôm nay ngày 25 tháng 6 năm 2026 - Xổ số Vietlott Power 6/55 hôm nay.
-
Kinh tế xã hộiXSAG 25/6. Kết quả xổ số An Giang hôm nay 25/6/2026
Bnews. XSAG 25/6. Kết quả xổ số hôm nay ngày 25/6. XSAG Thứ Năm. Trực tiếp KQXSAG ngày 25/6. Kết quả xổ số An Giang hôm nay ngày 25/6/2026. Kết quả xổ số An Giang Thứ Năm ngày 25/6/2026.